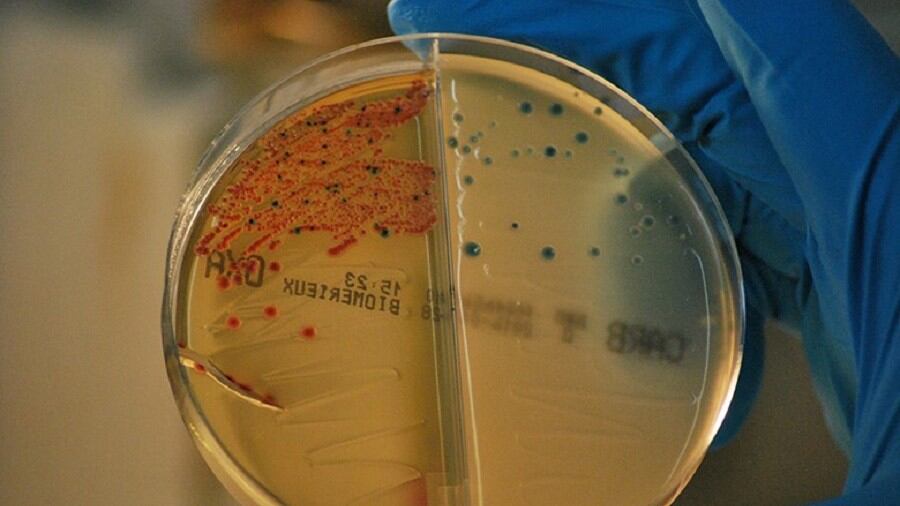

MADRID, 18 (EUROPA PRESS)
Así lo ha detallado este viernes en una jornada la ministra de Sanidad, Carolina Darias, con motivo del Día Europeo para el Uso Prudente de los Antibióticos, que se celebra hoy.
Coincidiendo con este Día Europeo se han publicado los informes de consumo de antimicrobianos a nivel europeo en sanidad animal y en salud humana. Así, en sanidad animal, se ha publicado el 12º Informe ESVAC correspondiente al consumo de antibióticos veterinarios en 2021 en 31 Estados Miembros.
En el informe se puede observar como España ha disminuido en un 62,5 por ciento el consumo de antibióticos veterinarios desde el año 2014, año de inicio del PRAN, hasta 2021.
El documento apunta que, si bien es cierto que la tendencia en la disminución del consumo es muy favorable, se puede apreciar un ligero aumento del consumo del 1,8 por ciento desde el año 2020 al año 2021.
A pesar de ello, España presenta la evolución más favorable de los 31 Estados Miembros que participan en el informe ESVAC. Esto se demuestra, sobre todo, en la disminución del consumo de antibióticos de importancia crítica del 91,5 por ciento desde 2014 a 2021 y del 10,5 por ciento en el último año, a pesar del pequeño incremento general.
Por su parte, en salud humana, el Centro Europeo para el Control y la Prevención de Enfermedades (ECDC, por sus siglas en inglés) ha publicado el informe de consumo ESAC-Net, detallando el consumo de antimicrobianos hasta el 2021 de 29 países europeos.
En él se pueden contextualizar la reducción del 25,5 por ciento en el consumo de antibióticos en España con el resto de países, así como la diferencia en el consumo entre el año 2020 y el primer año tras el inicio de la pandemia.
En el caso concreto de nuestro país, ha habido una ligera subida del 1,3 por ciento respecto al 2020. Sin embargo, España ha mejorado un puesto en la posición global respecto al resto de países, indicando que la tendencia europea también ha sido al alza en el pasado año 2021.
Con todo ello, España es el séptimo país, de todos los que han reportado al ECDC sus datos de consumo, que mayor reducción ha tenido en los últimos años.
"La resistencia a los antibióticos es una cuestión prioritaria para cualquier sistema de salud, tanto por su magnitud como por su impacto en la salud pública. Causa miles de muertos en Europa. Fue declarada en 2020 por la Organización Mundial de la Salud (OMS) como una de las principales amenazas para la salud pública a la que nos enfrentamos como humanidad", ha advertido Darias.
La ministra ha asegurado que el nuevo PRAN, fechado para los años 2022-2024, "va a permitir seguir avanzando en la consolidación de la vigilancia y la mejora de los consumos de antibióticos". "La lucha frente a la resistencia antimicrobiana presenta retos que debemos abordar conjuntamente", ha agregado al respecto.
De hecho, tal y como ha recordado Darias, en los últimos cinco años solo han superado la fase regulatoria de aprobación 12 antibióticos, de los que diez pertenecen a una clase que "ya se enfrenta a resistencias", según datos de la OMS.
Tras la intervención de la ministra, la directora de la AEMPS, María Jesús Lamas, ha puesto en valor los logros del PRAN y ha presentado los nuevos retos y acciones del PRAN 2022-2024. También ha anunciado la presentación de las Normas de Certificación de equipos PROA hospitalarios y comunitarios para principios de 2023, y los trabajos que se están realizando para mejorar la herramienta de mapas de consumo.
En sanidad animal, ha destacado el "fortalecimiento del diálogo" con los diferentes sectores gracias a "la nueva organización de los grupos de trabajo, la vigilancia de bacterias patógenas clínicas y la mejora de la disponibilidad de antimicrobianos y alternativas".
TESTIMONIO DE AFECTADOS
Durante la jornada, organizada por la Agencia Española de Medicamentos y Productos Sanitarios (AEMPS), se ha intentado acercar este problema de salud pública la población a través de las vivencias compartidas por afectados por una infección producida por bacterias resistentes a antibióticos.
Daniel Río, que se ha visto afectado durante años por una infección causada por una bacteria multirresistente, ha contado cómo tuvo que cambiar su vida, hasta el punto de llegar a perder parte de la audición y tener que realizar sus estudios de manera 'on line'.
Al respecto, la directora del Grupo Virología Ambiental y Biomédica I2SysBio de la Universitat de Valencia-CSIC, Pilar Domingo-Calap, ha expuesto el papel de la fagoterapia como alternativa a los antibióticos en este tipo de casos en los que ningún antibiótico consigue vencer a la bacteria.
A continuación, Rosa Vallori, veterinaria clínica igualmente afectada por una infección producida por una bacteria resistente, y Christian de la Fe, profesor del Departamento de Sanidad Animal de la Universidad de Murcia, han abordado la sanidad animal y su vínculo con la salud humana y el medio ambiente, junto a los coordinadores del PRAN Cristina Muñoz y Ricardo Carapeto.
La jornada ha continuado con un diálogo abierto entre Marián García y la doctora Lucía García Bertrand, reconocida pediatra y escritora, en el que han narrado sus experiencias en consulta y las situaciones con las que se encuentran en su día a día como profesionales de la salud.
Para finalizar, la secretaria de Estado de Sanidad, Silvia Calzón, ha hecho entrega de los premios PRAN que reconocen y dan visibilidad a aquellas iniciativas que han contribuido "de forma sobresaliente" a la consecución de las metas de la estrategia nacional frente a la resistencia bacteriana.
El Día Europeo para el Uso Prudente del Antibiótico es una iniciativa europea de salud pública anual que se celebra el 18 de noviembre. Su objetivo es sensibilizar sobre la amenaza que la resistencia a los antibióticos supone para la salud pública y fomentar el uso prudente de los mismos.
Con motivo de este día, el PRAN desarrolla diferentes iniciativas como la II edición de '¡Corre sin resistencias!', la carrera PRAN que este año ha tenido más de 2.000 participantes y se ha celebrado en 9 ciudades españolas y otros eventos deportivos asociados al PRAN.
Por otra parte, durante este periodo se está difundiendo en medios digitales la campaña 'Antibióticos, ¡tómatelos en serio!', para informar de que los antibióticos no curan las infecciones causadas por virus, como el resfriado común o la gripe, y únicamente son eficaces para combatir las infecciones bacterianas. El objetivo es concienciar sobre el diagnóstico correcto y poner en valor que la decisión respecto a la necesidad de administrar antibióticos son competencia exclusiva de los médicos.